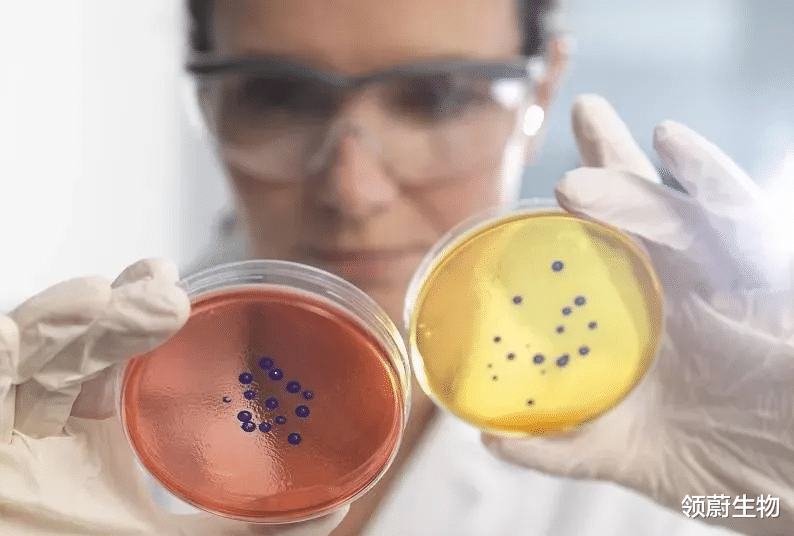

领蔚生物|研究综述:干细胞疗法对糖尿病相关病变的临床试验

文章图片

文章图片

文章图片

文章图片
据IDF(国际糖尿病联合会)发布的第八次全球糖尿病概览 , 截至2017年全球糖尿病患者约4.25亿 , 我国糖尿病人数达1.14亿人 , 占全球患者人数的1/3 。
糖尿病(DM)是威胁人类健康的三大慢性非传染性疾病之一 , 随着病情逐步加重 , 还伴有其他严重并发症 , 对人类生存质量产生一定影响 。
长期血糖增高 , 大血管、微血管受损并危及心、脑、肾、周围神经、眼睛、足等 , 常见糖尿病导致的病变有 , 糖尿病肾病、糖尿病病足、糖尿病视网膜病变、糖尿病心肌病变等 。
近年来 , 随着人们对干细胞的科学研究越发透彻 , 科学家发现干细胞是治疗糖尿病的良好方法 。
MSCs作为治疗DM的新型代表方法 , 具有胰岛素分泌细胞潜能、免疫调控、抗炎和组织损伤修复等功能 。
由于MSCs具有多向分化能力 , 可以分泌多种细胞因子 , 参与免疫调节、血管再生等病理生理作用 , 且伦理问题较少 , MSCs已经成为一种具有良好前景的DM治疗方法 。
MSCs移植对DM动物血糖的调节作用临床前动物研究结果显示:MSCs移植控制高血糖的机制可能是直接分化成胰岛素分泌细胞 , 通过免疫调节机制阻止内源性T细胞对胰岛β细胞的损伤 , 或通过某些未知因素影响胰岛素的分泌 。
研究者通过对DM小鼠进行骨髓MSCs移植发现:这些细胞并未明显降低血糖水平 , 而是降低了胰腺损伤程度 。
MSCs对DM相关病变的治疗作用MSCs对糖尿病视网膜病变(DR)的治疗作用
DR是DM患者主要的微血管并发症 , 损害视网膜 , 严重影响患者视力 。
李丽对影响DR的相关因素进行分析发现:年龄、文化程度、血压、血糖和遗传因素均与DR的发病有关联 。
传统疗法:目前增殖性DR主要采用激光光凝术进行治疗 , 该方法可破坏缺氧的视网膜 , 避免产生新生血管 , 并使其消退 , 保护部分视网膜 , 挽救视力 , 但可能会导致视野缺损及视力丧失等严重后果 。
研究显示:MSCs能够有效改善模型大鼠血视网膜屏障功能 , 对修复大鼠血视网膜屏障损伤起积极作用 , 可明显降低模型动物的血糖水平 。
动物模型实验结果提示:移植MSCs可对视网膜病变起一定的治疗作用 , 但其具体治疗方式及安全性仍需进一步探讨 。
MSCs对DN的治疗作用DN是DM常见的并发症和主要死亡原因之一 , 在1型或2型DM人群中DN发病率均较高 。 高血糖、高血压、肥胖和血脂异常等均是目前已知的促进DN发生发展的危险因素 。 在这些危险因素中 , 很多都可以通过改善生活习惯等进行改善起到良好的效果 , 减少或延迟DN的发生 。 DN的发病与多种因素有关 , 包括遗传、糖代谢紊乱、致纤维化细胞因子、炎症反应和氧化应激等 , 但尚未完全清楚 。
研究显示:骨髓MSCs可定向迁移至受损的肾脏 , 分泌细胞因子 , 并调节免疫反应 , 保护肾功能和结构 , 修复肾脏损伤 。 MSCs能清除细胞的毒性分子或促进血管再生 , 减轻对肾脏的损害 , 改善肾脏血供;MSCs还可分化为胰岛素分泌细胞 , 降低血糖、尿糖水平及损害肾细胞的重要因子 。 MSCs对糖尿病周围神经病变 (DPN)的治疗作用DPN为常见DM慢性并发症之一 , 临床症状表现较早 , 易误诊 , 主要表现为双下肢感觉减退或缺失 , 随病情加重可导致坏疽而进行截肢 。 目前DPN的治疗效果并不理想 。
经验总结扩展阅读
- 用户「众测研究团」谁也逃不过真人实测!400人实测霓姿多功能美容仪
- 原料发挥第四代生物活性化妆品优势,拾妆护肤品沉下心做产品
- 功效水解小分子透明质酸钠-舒敏抗炎修复效果研究
- |帮女友抢九价HPV疫苗,研究生发现商机!警方:犯法了
- 辞退|研究表明,中年人“失业”成为了趋势,关键原因有这4点
- @qq深圳钰美生物28天祛斑宣传是否存在夸大宣传
- 成功10年老斑有救啦!伯朗基美肤水,开启生物焕颜之旅!
- 连体裤 间歇性禁食会是肥胖人士的“救星”吗?来看看研究怎么说
- 分手|研究上百个情感案例发现,两个人缘分已尽,都是有征兆的
- 研究揭秘:为什么长得太好看,对找工作并不利?











